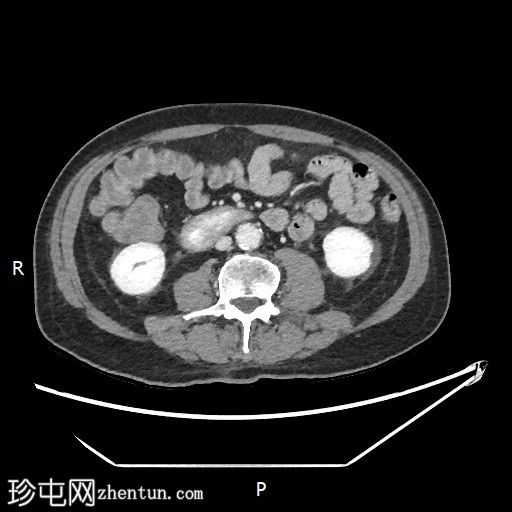
3.jpg

病例介绍
梅莱娜
患者资料
年龄:70岁
性别:男
CT
轴位
平扫

轴位增强扫描
动脉期

轴位增强扫描
门静脉期
冠状位增强扫描
动脉期

冠状位增强扫描
门静脉期

胃内出血
造影剂外渗提示十二指肠第二段活动性出血

十二指肠第三段造影剂积聚
活动性出血

肺底不张
上消化道内镜检查

照片
十二指肠壁溃疡
十二指肠壁溃疡

食管炎
止血
及止血夹
胃底可见变质血液
内镜报告:
食管:LA C级食管炎。
胃:胃底可见变质血液及大血块。吸痰、冲洗并调整患者体位以移动血块后,未在胃底或胃体部发现病变。未发现活动性出血点。
胃窦:幽门前区可见三处溃疡,每处均小于1厘米,底部均清洁。
十二指肠:
D1:D1前壁可见一处含血块的溃疡。应用两个止血夹止血,并在溃疡周围注射1:10,000肾上腺素。
D2:D2可见两处溃疡。
病例讨论
CT血管造影对检测活动性消化道出血具有较高的敏感性。
患者立即接受了上消化道内镜检查。 |